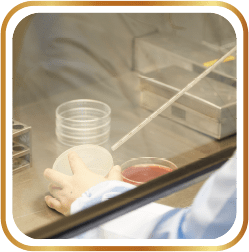

達智
集點







維生素B1-促進食慾
維生素D-幫助鈣吸收
維生素C-幫助鐵吸收

| 半乳寡醣(GOS)- | 益生菌生長 便便柔軟 |
5種核苷酸-提升自我保護力

DHA-啟動學習關鍵
5磷脂-強化反應力
資料來源:1.Yoshihama,M.et al., Reports of Rearch Laboratory, Snow Brand 78.33(1982) 2. Mitsuhashi,M.et al., Reports of Rearch Laboratory, Snow Brand 78. 49(1982) 3. European Journal of Clinical Nutrition volume 56, pagesS1–S4 (2002) 4. Birch EE, et al. A randomized controlled trial of early dietary supply of long-chain polyunsaturated fatty acids and mental development in term infants, Dev Med Child Neurol. 2000; 42: 174-1815. Dietary phospholipids: Role in cognitive processes across the lifespan

資料來源:1.雪印調查2.中島博德, 高橋謙太郎:ビフィズス, 本間道, 光岡知足 共編, p186, 日本學會事務センター事業部(1979)3. Atul Singhal et al. The American Journal of Clinical Nutrition, Volume 87, Issue 6, June 2008, Pages 1785–1792

雪印達智成長配方,適合銜接母乳
提升乳清蛋白的比例,
降低酪蛋白比例
,讓蛋白質更好吸收
資料來源:1.神經鞘磷脂 SPM 、磷脂醯乙醇胺 PE 、磷脂醯肌醇 PI 、磷脂醯絲胺酸 PS 、磷脂醯膽鹼 PC
。Dietary phospholipids: Role in cognitive processes across the lifespan





資料來源:*FAO/WHO,Human Vitamin and Mineral Requirements-1-3遂建議攝取量
國際認證工廠
FSSC22000

精湛工藝
噴霧造粒技術
保留珍稀營養

貼近自然口感

造粒技術
配方易溶解
好沖調

安全衛生
輕鬆計量

830g/罐

14gx10包/盒
Copyright© 台灣雪印 Snow Brand Taiwan CO., LTD. All right reserved.

